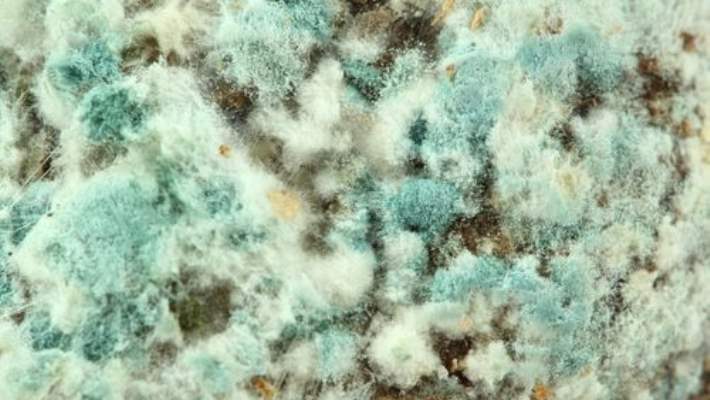

- İçindekiler
- Nedir
- Belirtileri
- Sebepleri
- Risk Faktörleri
- Komplikasyonları
- Muayenesi
- Testleri
- Tedavisi
- Yaşam Tarzı
- Önleme

Nedir
Küf Alerjisi
Eğer küfe alerjiniz varsa, küf sporlarını soluduğunuzda bağışıklık sisteminiz aşırı reaksiyon gösterir. Bu reaksiyon, alerji belirtilerine yol açan reaksiyonlar zincirini ateşler. Tıpkı diğer alerjiler gibi küf alerjisi de öksürük, gözlerde kaşıntı ve sizi rahatsız edecek diğer belirtilere yol açar. Küf alerjisi, bazı insanlarda astımla ilişkilidir ve küfe maruz kalmak, nefes darlığına ve diğer solunum yolları rahatsızlıklarına neden olur. Eğer küf alerjiniz varsa en iyi tedbir, reaksiyonunuza neden olan küf türlerine maruz kalmayı azaltmaktır. Küf alerjisi tetikleyicilerinden kaçınmak, her zaman mümkün olamazken ilaçlar reaksiyonların kontrol altında tutulmasına yardım edebilir.
Belirtileri
Belirtileri
Küf alerjisi, diğer üst solunum yolu alerjisi türlerinde de görülen benzer belirtilere sebep olur. Küf alerjisi belirtileri şunlardır:
- Hapşırma
- Burun tıkanıklığı veya burun akıntısı
- öksürük ve geniz akıntısı
- Göz, burun ya da boğazda kaşıntı
- Göz sulanması
Küf alerjisi belirtileri, kişiden kişiye ve hafiften şiddetliye değişir. Sadece yılın belli zamanlarında alevlenen belirtiler ya da yıl boyunca belli bir döngüde seyreden belirtiler yaşıyor olabilirsiniz. Hava nemlendiğinde ya da küf konsantrasyonunun yüksek olduğu iç ya da dış mekanlarda belirtilerinizi fark edebilirsiniz. Eğer küf alerjiniz ve astımınız varsa küf sporlarına maruz kaldığınızda astım belirtileriniz başlayabilir. Belli küf türlerine maruz kalmak, bazı kişilerde şiddetli astım ataklarına neden olur. Astımın belirtileri şunlardır:
- öksürük
- Hırıltı
- Nefes tıkanıklığı
- Göğüs sıkışması
Doktora ne zaman gidilir?
Eğer burun tıkanıklığı, hapşırık, göz sulanması ya da geçmeyecek gibi görünen diğer belirtileriniz varsa doktorunuza görünün.
Sebepleri
Nedenleri
Diğer tüm alerjiler gibi küf alerjisi belirtileri de bağışıklık sistemin aşırı duyarlılığından kaynaklanır. Havada uçuşan küçük küf sporlarını soluduğunuzda vücudunuz bunları yabancı istilacı olarak tanımlar ve savaşmak için alerjiye neden olan antikorlar geliştirir. Küfle temasınız kesildikten sonra bile, bağışıklık sisteminiz hala bu istilacıları hatırlayan antikorlar üretir. İlerde küfle herhangi bir temasta bulunmak, bağışıklık sisteminizin reaksiyon göstermesine neden olur. Bu reaksiyon; kaşıntı, göz sulanması, burun akıntısı, hapşırma ve diğer küf alerjisi belirtilerine yol açan maddelerin salınmasını ateşler. Küfler, hem iç mekanlarda hem dış mekanlarda çok yaygındır. Birçok türü vardır, ancak belli türdeki küfler alerjiye neden olabilir. Bir tür küfe alerjiniz olması, başka bir türüne alerjik olmayacağınız anlamına gelmez. Yaygın olarak alerjiye neden olan küflerden bazıları; alternaria, aspergillus, cladosporium ve penicilliumdur.
Ne zaman alerji değildir?
Küf alerjisi, küfe maruz kalmanın ortaya çıkardığı en yaygın sorun olmasına karşın küf, alerjik reaksiyon olmayan bir hastalığa da sebep olabilir. Alerji, enfeksiyonlara ya da tahriş edici ve zehirleyici reaksiyonlara da yol açabilir. Küften kaynaklanan enfeksiyonlar, grip benzeri sorunlardan cilt enfeksiyonları ve zatürreye kadar bir dizi değişik soruna yol açabilir. ‘Uçucu organik bileşikler olarak adlandırılan ve küften kaynaklanan bazı maddeler, vücuttaki mukus çeperlerini tahriş eden bir reaksiyona sebep olurlar. Bu reaksiyonun belirtileri, alerjiye benzerdir.Belirtiler arasında göz tahrişi, burun akıntısı, öksürük, ses bozukluğu, baş ağrısı ve cilt tahrişlerini bulunur. Küf alerjisinde belirtileriniz genel olarak, küfe her maruz kaldığınızda artarak kötüleşme gösterir, ama tahriş edici reaksiyonlar kötüleşmez. Toksik bir küf reaksiyonuna; ‘mantar zehiri olarak adlandırılan maddeleri yemek, içmek ya da solumak sebep olur. Tahriş edici bir reaksiyonda olduğu gibi toksik reaksiyon belirtileri de grip benzeri belirtileri, göz ve cilt tahrişlerini ve nefes alma güçlüklerini içerir. Eğer küfe toksik reaksiyonunuz varsa ayrıca baş ağrısı, sinirlilik, baş dönmesi, konsantrasyon güçlüğü ve aşırı yorgunluk yaşarsınız.
Risk Faktörleri
Risk faktörleri
Birçok faktör, sizin küf alerjisi geliştirme riskinizi arttırır ve var olan belirtilerinizi kötüleştirir:
- Ailenizin alerji geçmişi. Eğer ailenizde alerjiler ve astım yaygınsa, küf alerjisi geliştirme riskiniz daha yüksektir.
- Sizi, küfe maruz bırakan bir meslekte çalışmak. Küfe maruz kalmanın yüksek olduğu meslekler; çiftçilik, süt ürünleri işleri (mandıracılık), kerestecilik, fırıncılık, tahta işleri, marangozluk, seracılık, şarap yapımı ve mobilya tamiri işlerini kapsar.
- Yüksek rutubetli bir evde yaşamak. Eğer evin içindeki nem yüzde 60 tan fazlaysa yüksek düzeyde küfe maruz kalabilirsiniz. Eğer koşullar uygunsa küf, fiilen her yerde gelişebilir; tabanda, duvar kaplamalarının arkasında, köpük kaplı sıvalarda, diğer nemli yüzeylerde, halı altlıklarında ve halılarda. Yüksek düzeyde ev küfüne maruz kalmak, küf alerjisi belirtilerini başlatabilir.
- Aşırı rutubete maruz kalmış olan binada çalışmak ya da yaşamak. Sızdıran borular, yağmur sırasında sızıntılar, sel hasarları gibi nedenlerle, neredeyse her bina bir miktar neme sahiptir. Bu nem, küfün gelişmesine olanak sağlar.
- Havalandırması kötü olan bir evde yaşamak. Sıkı pencereler ve sıkı kapılar küfü içeride tutabilir ve uygun havalandırmayı engeller, bu da küfün gelişmesi için ideal ortamı sağlar. Banyolar, mutfaklar ve bodrum gibi rutubetli ortamlar küf oluşmasına en uygun ortamlardır.
Komplikasyonları
Komplikasyonlar
Küfe karşı çoğu alerjik tepki, saman nezlesinde olduğu gibi sizi perişan edecek belirtilere yol açar, ama bunlar şiddetli değildir. Ancak, küfün sebep olduğu belli alerjik rahatsızlıklar daha şiddetlidir. Bu tepkiler şunlardır:
- Küf kaynaklı astım. Küfe alerjisi olan insanlarda küf sporlarını solumak, astımın alevlenmesini tetikleyebilir. Eğer küf alerjiniz ve astımınız varsa, şiddetli bir astım atağı durumunda uygulayabileceğiniz acil bir planınız olsun.
- Alerjik mantar sinüziti. Mantarlar sinüsünüze yerleştiğinde ve geliştiklerinde meydana gelir. çok şiddetli sinüs enfeksiyonunu iyileştirmek için ameliyat gerekebilir.
- Alerjik bronkopulmoner aspergillozis. Akciğerlerdeki bu mantar enfeksiyonu, astımı ya da sistik fibrozisi olan insanlarda meydana gelir.
- Aşırı duyarlılık zatürresi (aşırı duyarlılık pnömonisi). Seyrek görülen bu rahatsızlık, küf sporları gibi havada uçan zerrecikler solunduğunda meydana gelir ve akciğerlerin iltihaplanmasına yol açar. İşyerindeki tozlara maruz kalmakla da tetiklenebilir.
Küfün neden olduğu diğer sorunlar
Bazıları, belli küflerin (siyah küf gibi); yorgunluk, baş ağrısı, mide bulantısı, ateş, isilik ve öksürük gibi belirtilere yol açabileceğine ve hatta bebeklerde akciğer kanamasına (akut idiopatik akciğer kanaması) neden olabileceğine inanmaktadırlar. Bazı küfler, besinlere karıştığı zaman zehirleyici etki yapabilir. Binaların içindeki küflerin, sağlıklı insanlarda sorunlara yol açabilecek ve havada uçuşan toksinler yaydığını belirlemek için daha fazla çalışma yapılmasına ihtiyaç vardır. Rutubetli binalarda yaşamak ya da çalışmak burun tıkanıklığı, hapşırma, burun akıntısı, boğaz tahrişi ve öksürme gibi solunum yolları şikayetlerine yol açabilir. Ancak, küfün her zaman bu belirtilerden sorumlu olup olmadığı net değildir. çünkü rutubetli binalar; zararlı bakteriler, toz akarları ve kemirgenler gibi diğer zararlılar için de uygun ortamlardır. Yüksek düzeyde küfe maruz kalmak, bağışıklık sistemi zayıf kişilerde alerjik olmayan komplikasyonlara yol açabilir. Eğer sağlıklıysanız küfe maruz kalmakla baş edebilirsiniz. Ama eğer kemoterapi ya da bağışıklık sistemini baskılayıcı ilaçlar alıyorsanız küf alerjisi geliştirme riskiniz yüksek olabilir.
Muayenesi
Randevunuza hazırlık
Eğer küf alerjisiyle bağlantılı olabilecek hapşırık, öksürük, göz sulanması gibi şikayetleriniz varsa muhtemelen önce aile doktorunuza görünebilirsiniz. Ancak, alerjinizin şiddetine ve yaşamınızdaki etkilerine bağlı olarak doktorunuz, sizi, alerjilerin tedavisinde uzmanlaşmış bir doktora (alerjist) yönlendirebilir. Sizin için önemli olan konuları konuştuğunuzdan emin olmak için önceden hazırlık yapabilirsiniz. Burada, randevunuza hazırlanmanıza yardım edecek bazı bilgiler ve doktorunuzdan bekleyebilecekleriniz yer almaktadır.
Siz ne yapabilirsiniz?
- Randevu öncesinde uymanız gereken herhangi bir kısıtlama olup olmadığını sorun. örneğin, alerji testi yaptıracaksanız doktorunuz testten önceki birkaç gün süreyle almakta olduğunuz alerji ilaçlarını kesmenizi isteyebilir.
- Yaşadığınız tüm belirtileri yazın. Buna, belirtileriniz olduğu zaman neler yaptığınızı da ekleyin.
- Aldığınız bütün ilaçların, vitaminlerin ya da desteklerin listesini yapın. Yaptığınız bu listeyi beraberinizde randevunuza götürün.
- Doktorunuza soracağınız soruları yazın.
Soruların bir listesini hazırlamak, doktorunuzla geçireceğiniz zamandan en iyi şekilde yararlanmanızı sağlar. Küf alerjisi için sorabileceğiniz bazı sorular şunlar olabilir:
- Bu belirtilere neyin sebep olduğunu düşünüyorsunuz?
- Belli bir alerjiyi teyit edecek testler var mı? Bu testlere hazırlanmam gerekiyor mu?
- Küf alerjisini nasıl tedavi edebilirim?
- Alerji ilaçlarından nasıl yan etkiler beklemeliyim?
- Evimdeki küften kurtulmak için hangi adımları atabilirim?
- Reçete etmekte olduğunuz ilacın muadili var mı?
- Başka sağlık sorunlarım da var. Bu rahatsızlıkları birlikte en iyi nasıl yönetebilirim?
- Eve beraber götürebileceğim herhangi bir broşürünüz ya da başka yazılı materyaliniz var mı? Ziyaret etmemi tavsiye edeceğiniz bir web sitesi var mı?
Doktorunuzdan bekleyebilecekleriniz
Belirtilerinizden sorumlu olan alerjileri ve diğer muhtemel nedenleri belirlemek için doktorunuz size birçok soru soracaktır. Doktorunuz şunları bilmek isteyebilir:
- Tam olarak hangi belirtilerinizin olduğunu
- Belirtilerinizi başlatanın ya da onları kötüleştirenin nelermiş gibi göründüğünü
- Belirtilerinizin yılın belli bir döneminde mi, yoksa günün belli zamanlarında mı kötüleştiğini
- Belirtilerinizin dışarıda ya da evin bodrumu gibi belli ortamlarda mı alevlendiğini
- Bitkisel çareler de dahil hangi ilaçları aldığınızı
- Başka sağlık problemlerinizin olup olmadığını
- Ailenizde alerji geçmişinin olup olmadığını
- İş yerinizde küf, toz, duman ya da kimyasallara maruz kalıp kalmadığınızı
- Evinizde küflü bir ortam olduğunu bilip bilmediğinizi
Bu arada siz ne yapabilirsiniz?
Doktoru ziyaret etmeyi beklerken, belirtilerinizi hafifletmek için loratadine, cetirizine, diphenhydramine, clemastine ve chlorpheniramine gibi çeşitli reçetesiz ilaçlar kullanabilirsiniz. Eğer evinizde küf varsa o bölgenin, küfe alerjisi olmayan birisi tarafından yaklaşık 30 ml çamaşır suyunu, 1 litre suya karıştırarak veya ticari olarak satılan küf temizleme ürünüyle temizlemeyerek, belirtilerinizin azalmasına yardım edebilir. Eğer küfü kendiniz temizlemek zorundaysanız, uzun kauçuk eldivenler giydiğinizden ve güvenlik gözlükleri ile küfe maruz kalmanızı sınırlayacak maske taktığınızdan emin olun.
Testleri
Testler ve teşhis
Doktorunuz belirtilerinizi bilmek isteyecektir ve başka sağlık sorunlarınızı bertaraf etmek ya da belirlemek için sizi, fiziksel muayeneden geçirecektir. Doktorunuz ayrıca, tanımlanabilecek bir alerjiniz olup olmadığını görmek için bir veya daha fazla cilt ya da kan testi isteyebilir. Bu testler şunlardır:
- Deri prik testi. Test, lokal bölgelerde bulunan yaygın küfler ya da şüphe edilen alerjenlerin çok küçük bir miktarını kullanır. Test sırasında, küf ya da alerjenler, kolunuzun ön ya da arka kısmına ince bir delmeyle uygulanır. Eğer alerjikseniz, cildinizin üzerindeki test bölgesinde kızarık bir tümsek (şişkinlik) geliştirirsiniz.
- Kan testi. Bazen radioallergosorbent (RAST) testi olarak da adlandırılan kan testi, kan dolaşımınızda immünoglobülin E (IgE) antikorlarının miktarını ölçerek, bağışıklık sisteminizin küfe tepkisini ölçebilir. Alınan kan örneği, özel küf türüne duyarlılık kanıtlarının test edilebileceği bir tıbbi laboratuvara gönderilir.
Tedavisi
Tedaviler ve ilaçlar
Bütün alerjiler için en iyi tedavi, alerjenlerinize maruz kalmaktan kaçınacak adımları atmaktır. Ancak küfler yaygındırlar ve bunlardan tümüyle kaçmanız mümkün olmayabilir. Bir küf alerjisini tedavi etmenin kesin bir yolu yoktur, ama birçok ilaç belirtilerinizi hafifletebilir. Bunlar şunlardır:
- Burun kortikosteroidleri. Söz konusu burun spreyleri, üst solunum yolu küf alerjisinin sebep olduğu iltihabın tedavisine ve önlenmesine yardım eder. Birçok insan için bunlar en etkili alerji ilaçlarıdır ve çoğunlukla ilk reçete edilen ilaçlardır. örnekler, ciclesonide, fluticasone, mometasone ve beclomethasone içeren ilaçları kapsar. Bu ilaçların en yaygın yan etkisi, burun kanamasıdır, ancak uzun dönemli kullanımlarda genellikle güvenlidirler.
- Antihistaminler. Bu ilaçlar kaşıntı, hapşırma ve burun akıntısına faydalıdır. Söz konusu ilaçlar bir alerjik reaksiyon sırasında bağışıklık sisteminizin salgıladığı iltihabi kimyasalları ve histaminleri engelleme işlevi görür. Reçetesiz antihistaminler loratadine ve cetirizine yi) kapsar. Diphenhydramine ve clemastine gibi eski antihistaminler de fayda edebilir, ama sizi uyuşuk yapabilirler. Fexofenadine ve burun spreyi azelastine reçeteli satılan ilaçlardır.
- Dekonjestanlar (tıkanıklık gidericiler). Bu ilaçlar, reçetesiz ve reçeteli sıvılar, tabletler ve burun spreyleri olarak bulunurlar. Reçetesiz olan ve ağızdan alınan tıkanıklık gidericilerdir. Burun spreyleri phenylephrine ve oxymetazoline yi içerir. Ağızdan tıkanıklık gidericiler tansiyonu yükseltebildiğinden yüksek tansiyonunuz varsa, bunlardan kaçının. çok uzun periyotlarla kullanıldığı zaman tıkanıklığın yeniden gelişmesine sebep olabildiğinden, tıkanıklık açıcı burun spreylerini her seferde 2 ila 3 günden fazla kullanmayın.
- Kromolin (burun kromu). Bu ilaç, reçetesiz burun spreyi olarak mevcuttur. Histamin salınımını önleyerek küf alerjisi belirtilerını iyileştirmeye yardım eder. Kromolin en iyi etkiyi, belirtiler gelişmeden önce almaya başladığınızda gösterir.
- Montelukast. Montelukast, aşırı salya gibi alerji belirtilerine yol açan bağışıklık sistemi kimyasalları olan lökotriyenlerin hareketlerini engelleyen reçeteli bir ilaçtır. Alerjik astımda etkili olduğu kanıtlanan montelukast içerikli ilaçlar, ayrıca küf alerjisinin tedavisinde de etkilidir. Antihistaminler gibi bu ilaç da solunan kortikosteroidler kadar etkili değildir. Genellikle burun spreylerinin tolere edilemediği ya da hafif astımın olduğu durumlarda kullanılır.
Küf alerjisi için diğer tedaviler şunları kapsar:
- İmmünoterapi. Tedavi bir seri alerji iğnesidir ve saman nezlesi gibi bazı alerjileri fiilen elimine eder. Bununla birlikte maalesef, alerji iğneleri küf alerjisine karşı sadece orta düzeyde etkilidir.
- Burun yıkaması. Tahriş edici burun şikayetleri için doktorunuz, burnunuzu tuzlu suyla yıkamanızı tavsiye edebilir. Reçetesiz satılan burun tuz spreyleri kullanabilir ya da kendi tuzlu su solüsyonunuzu kendiniz hazırlayabilirsiniz. Bunu yapmak için, kapatabileceğiniz bir kap içinde üç dolu tatlı kaşığı iyotsuz tuzu, bir tatlı kaşığı yemek sodasıyla karıştırın. Bu karışımdan bir tatlı kaşığı alın ve tuzlu su solüsyonunuzu hazırlamak için yaklaşık 225 gram suyla karıştırın. Eğer bir yanma ya da batma hissediyorsanız, gelecek sefere daha az tuz ve yemek sodası karışımı kullanın.
Doktorunuz eğer ayrıca küf kaynaklı astımınız, alerjik mantar sinüzitiniz, alerjik bronkopulmoner aspergillozisiniz ve aşırı duyarlı pnömoniniz varsa, ek tedaviler tavsiye edebilir.
Yaşam Tarzı
Yaşam tarzı ve ev çareleri
Küf alerjisi belirtilerini kendinizden uzak tutmak için şu önlemleri alın:
- Dışarıdan gelecek küften uzak kalmak için pencereleriniz kapalı uyuyun. Havada uçan küf sporları konsantrasyonu, havanın serin ve rutubetli olduğu sıralarda daha yüksek olma eğilimindedir.
- Toz maskesi takın. Eğer yaprakları toplamak, çimleri biçmek ya da organik gübreli ortamlarda çalışmak zorundaysanız küf sporlarını uzak tutmak için burnunuzun ve ağzınızın üzerini kaplayan toz maskesi takın.
- Belli zamanlarda dışarı çıkmaktan kaçının. örneğin, sağanak yağmurdan hemen sonra sisli ya da rutubetli havada veya hissedilen küf miktarı yüksek olduğunda dışarı çıkmaktan kaçının.
Önleme
önleme
Evinizde küf gelişmesini azaltacak adımlar atın. Şu ipuçlarını göz önünde bulundurun:
- Bodrumlardaki rutubet kaynaklarını yok edin; boru sızıntıları ya da zemin suyu sızıntıları gibi.
- Nem gidericiler kullanın. Evinizde rutubet ya da küf kokan bütün alanlarda rutubet gidericiler kullanın. Rutubeti yüzde 50 nin altında tutun. Rutubet gidericilerin, toplama kovalarını ve yoğunlaştırıcıları düzenli olarak temizlemeyi unutmayın.
- Klima kullanın ve yüksek verimlilikli hava filtresi (HEPA) aksesuarı özellikli merkezi klima sistemi kurun. HEPA filtresi, evinizin içinde havayı sirküle etmeden önce dışarıdaki küf sporlarını tutar.
- Fırınınızın filtresini değiştirin. Ayrıca klimanızın, fırınınızın filtresini de düzenli olarak değiştirin. Zorunlu ısıtma kanallarını kontrol ettirin ve gerekliyse temizlettirin.
- Bütün banyoların düzgün şekilde havalandırıldığından emin olun. Duş alma ya da banyo sırasında havalandırmayı çalıştırın ve havanın hemen kurumasını sağlayın. Eğer havalandırma fanınız yoksa duş alırken ya da banyo yaparken bir pencere ya da kapı açın.
- Banyo ve bodrum duvarlarının yüzeylerini düzenli olarak temizleyin. Temizliği, beyazlatıcı (çamaşır suyu) ile yapın.
- Yeraltı drenaj sistemini iyileştirin. Zemin suyu drenajını evinizden uzaklaştırmak için yaprakları ve sistem etrafındaki bitkileri yağmur oluklarından sık sık temizleyin.
- Organik gıda konteynırlarını temiz ve kuru tutun. Hasır, saman ya da kendir gibi maddelerden yapılan organik bitki konteynırlarını kuru tutun.
Hangi alerjiler astıma neden olur?
Dyt. MELTEM ŞENİZ TOKSOY
Merhabalar ben 20 yaşındayım küçüklükten beri mide ağrısı yaşıyorum besin alerjisi oldugmu öğrendim bana özel diyet listesi yapmanızı istirham ediyoru... devamı

Evinizdeki 10 Gizli Alerji Noktası
Toz Akarı (Mayt) Alerjisi
Küf Alerjisi
Alerjileriniz Kontrol Dışı Mı?
Toza Maruz Kalma